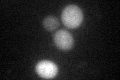

View description
Conserved protein required for assembly of alpha and beta subunits into the F1 sector of mitochondrial F1F0 ATP synthase; mutation of human ATP12 reduces active ATP synthase levels and is associated with the disorder ATPAF2 deficiency
Localization:
Intensity:
Fold change:
Significance:
-
C’ GFP library in SD

cytosol109.3 -
N' NOP1pr-GFP in SD

mitochondria19.2199 -
N' TEF2pr-mCherry in SD

mitochondria18.5519 -
N' NATIVEpr-GFP in SD

mitochondria23.695 -
N' TEF2pr-VC and Cyto-VN in SD

#N/A0 -
C’ GFP library in SD+DTT
cytosol53.710.49Yes -
C’ GFP library in SD+H2O2

cytosol123.171.12No -
C’ GFP library in Starvation Media

cytosol39.510.36No -
C’ GFP library on the background of Pup2-DaMP

cytosol -
C’ GFP library on the background of CCT mutant

cytosol106.4180.973528No
